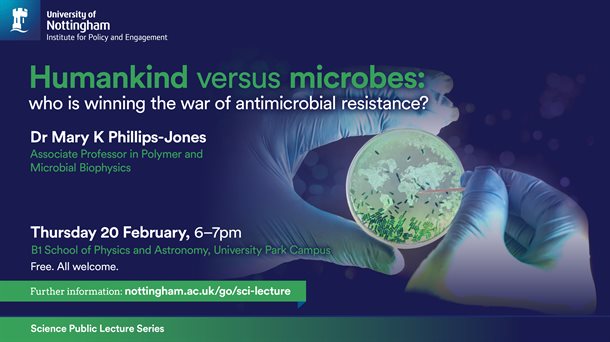
HumanVsMicrobes 1

The world is running out of antibiotics. The current modern Age of antibiotics started in the early 1900s with the pioneering work of Paul Ehrlich who discovered the antibacterial effects of dyes and who in 1909 discovered the arsenic-based Salvarsan to treat syphilis. Then came the famous discovery in 1928 by Alexander Fleming of penicillin, followed in the 1940s by the development of a purification method for the antibiotic by Howard Florey and Ernst Chain at the University of Oxford.
Overcoming microbial resistance by discovering new antibiotic classes is getting tougher. This presentation explores some of the approaches now being used to identify new antibiotic classes and/or overcome resistance, from development of synthetic antibiotics and exploitation of genomics through to what we can learn from Amazon ants, marine sponges and Komodo dragons.
This lecture, delivered by Dr Mary K Phillips-Jones will be taking place on Thursday 20 February, 6–7pm.
All are welcome to this free event, more information can be found here.